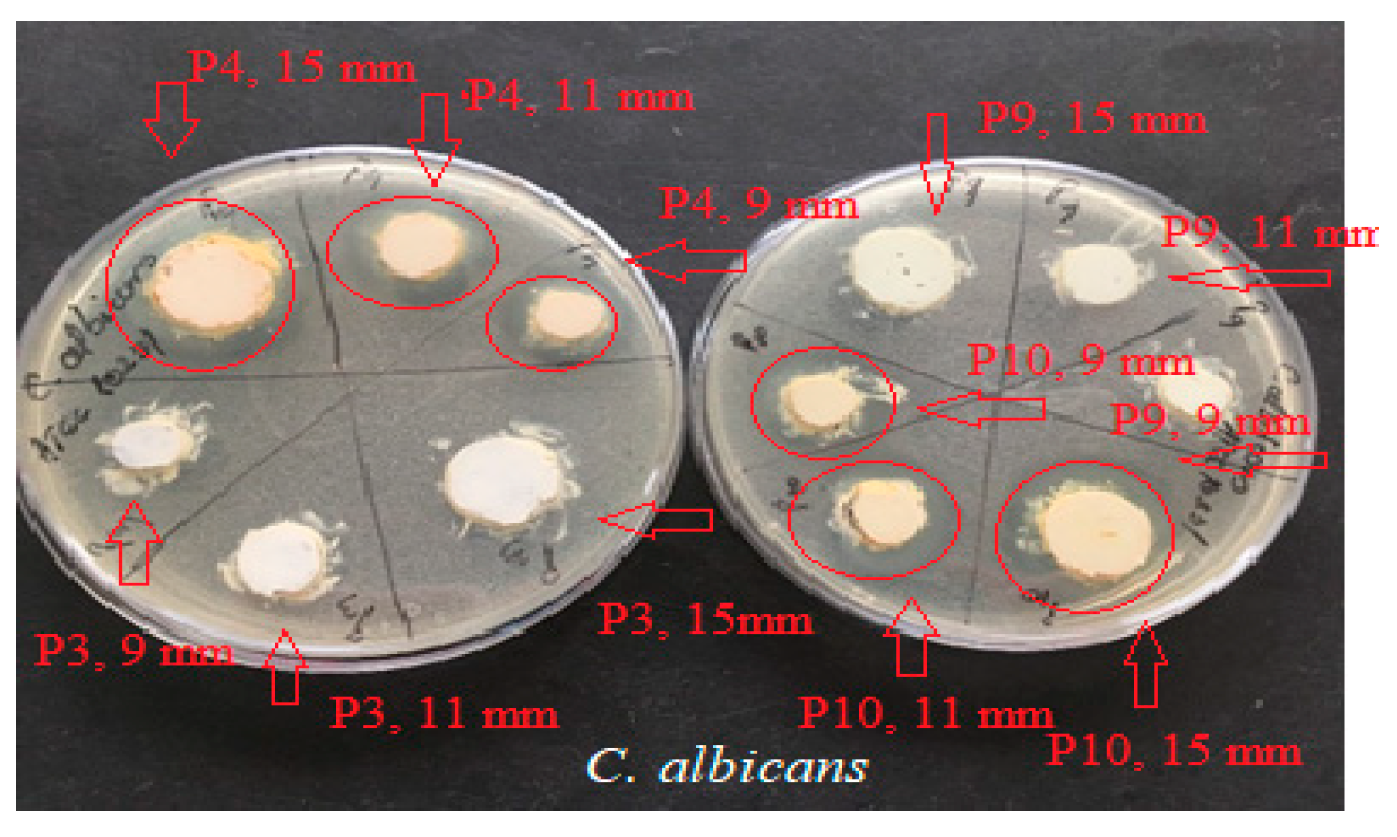
Ijms 24 16234 g005

Development of New Dermato-Cosmetic Therapeutic Formulas with Extracts of Vinca minor L. Plants from the Dobrogea Region
Abstract
:1. Introduction
2. Results
2.1. Characteristics of Vinca minor Extract-Based-Biocomposites
2.2. Rheological Behavior of Biocomposites
2.3. Determination of Antioxidant Activity for Vinca minor Extract-Based Biocomposites
2.4. Determination of Antimicrobial Activity for Vinca minor Extract-Based Biocomposites: Statistical Data Processing for Comparative Study of the Antimicrobial Effect of P3, P4, P9, and P10 Composites
2.5. Determination of Anti-Inflammatory Activity for Vinca minor Extracts Based Biocomposites
3. Discussion
4. Materials and Methods
4.1. Chemicals and Equipment
4.2. Preparation of Alcoholic Extracts from Vinca minor L.
4.3. Investigation Methods
4.3.1. Formulation of Semisolid Biocomposites
4.3.2. Rheological Measurements
4.3.3. Determination of Antioxidant Activity
4.3.4. Determination of Antimicrobial Activity
4.3.5. Determination of Anti-Inflammatory Activity
4.4. Statistical Data Processing
5. Conclusions
Author Contributions
Funding
Institutional Review Board Statement
Informed Consent Statement
Data Availability Statement
Acknowledgments
Conflicts of Interest
References
- Cordell, G.A.; Quinn-Beattie, M.L.; Farnsworth, N.R. The potential of alkaloids in drug discovery. Phytother. Res. 2001, 15, 183–205. [Google Scholar] [CrossRef]
- Karpus, I.P. Morpho-anatomical studies on Vinca minor L. from the family Apocynaceae. Farmatsevtychnyi Zhurnal 1961, 16, 48–52. [Google Scholar]
- Fleming. PDR for Herbal Medicines, 3rd ed.; Medical Economics Co.: Montvale, NJ, USA, 2004; pp. 632–663. [Google Scholar]
- Hasa, D.; Perissutti, B.; Cepek, C.; Bhardwaj, S.; Carlino, E.; Grassi, M.; Invernizzi, S.; Voinovich, D. Drug salt formation via mechanochemistry: The case study of vincamine. Mol. Pharm. 2013, 10, 211–224. [Google Scholar] [CrossRef] [PubMed]
- Pu, H.; Jiang, H.; Chen, R.; Wang, H. Studies on the interaction between vincamine and human serum albumin: A spectroscopic approach. Luminescence 2014, 29, 471–479. [Google Scholar] [CrossRef]
- Kapoor, A.; Mishra, S.K.; Verma, D.K.; Pandey, P. Chemical penetration enhancers for transdermal drug delivery system. J. Drug Deliv. Ther. 2018, 8, 62–66. [Google Scholar] [CrossRef]
- Williams, A. Topical and Transdermal Drug Delivery, 5th ed.; Aulton, M., Taylor, K., Eds.; Elsevier: London, UK, 2018; pp. 23–25. [Google Scholar]
- Grujić, S.M.; Radojević, I.D.; Vasić, S.M.; Čomić, L.R.; Topuzović, M.D. Antimicrobial and antibiofilm activities of secondary metabolites from Vinca minor L. Appl. Biochem. Microbiol. 2015, 51, 572–578. [Google Scholar] [CrossRef]
- Turker, H.; Yıldırım, A.B.; Karakaş, F.P. Sensitivity of Bacteria Isolated from Fish to Some Medicinal Plants. Turk. J. Fish. Aquat. Sci. 2009, 9, 181–186. [Google Scholar] [CrossRef]
- Yildirim, A.B.; Karakas, F.P.; Turker, A.U. In vitro antibacterial and antitumor activities of some medicinal plant extracts, growing in Turkey. Asian Pac. J. Trop. Med. 2013, 6, 616–624. [Google Scholar] [CrossRef] [PubMed]
- Nikolić, M.; Vasić, S.; Đurđević, J.; Stefanović, O.; Čomić, L. Antibacterial and anti-biofilm activity of ginger (Zingiber officinale (Roscoe)) ethanolic extract. Kragujev. J. Sci. 2014, 36, 129–136. [Google Scholar] [CrossRef]
- Wilson, C.L.; Solar, J.M.; El Ghaouth, A.; Wisniewski, M.E. Rapid evaluation of plant extracts and essential oils for antifungal activity against Botrytis cinerea. Plant Dis. 1997, 81, 204–210. [Google Scholar] [CrossRef]
- Rongai, D.; Milano, F.; Scio, E. Inhibitory Effect of Plant Extracts on Conidial Germination of the Phytopathogenic Fungus Fusarium oxysporum. Am. J. Plant Sci. 2012, 3, 1693–1698. [Google Scholar] [CrossRef]
- Pytlakowska, K.; Kita, A.; Janoska, P.; Połowniak, M.; Kozik, V. Multi-element analysis of mineral and trace elements in medicinal herbs and their infusions. Food Chem. 2012, 135, 494–501. [Google Scholar] [CrossRef] [PubMed]
- Jagani, S.; Chelikani, R.; Kim, D.S. Effects of phenol and natural phenolic compounds on biofilm formation by Pseudomonas aeruginosa. Biofouling 2009, 25, 321–324. [Google Scholar] [CrossRef] [PubMed]
- Huber, B.; Eberl, L.; Feucht, W.; Polster, J. Influence of polyphenols on bacterial biofilm formation and quorum-sensing. Z. Naturforschung C 2003, 58, 879–884. [Google Scholar] [CrossRef] [PubMed]
- Ciorîță, A.; Zăgrean-Tuza, C.; Moț, A.C.; Carpa, R.; Pârvu, M. The Phytochemical Analysis of Vinca L. Species Leaf Extracts Is Correlated with the Antioxidant, Antibacterial, and Antitumor Effects. Molecules 2021, 26, 3040. [Google Scholar] [CrossRef] [PubMed]
- Brown, T.L.; Petrovski, S.; Chan, H.T.; Angove, M.J.; Tucci, J. Semi-Solid and Solid Dosage Forms for the Delivery of Phage Therapy to Epithelia. Pharmaceuticals 2018, 11, 26. [Google Scholar] [CrossRef]
- Schmidberger, M.; Nikolic, I.; Pantelic, I.; Lunter, D. Optimization of Rheological Behavior and Skin Penetration of Thermogelling Emulsions with Enhanced Substantivity for Potential Application in Treatment of Chronic Skin Diseases. Pharmaceutics 2019, 11, 361. [Google Scholar] [CrossRef]
- Qwist, P.K.; Sander, C.; Okkels, F.; Jessen, V.; Baldursdottir, S.; Rantanen, J. On-line rheological characterization of semi-solid formulations. Eur. J. Pharm. Sci. 2019, 128, 36–42. [Google Scholar] [CrossRef]
- Neculai, A.M.; Stanciu, G.; Mititelu, M. Determination of Active Ingredients, Mineral Composition and Antioxidant Properties of Hydroalcoholic Macerates of Vinca minor L. Plant from the Dobrogea Area. Molecules 2023, 28, 5667. [Google Scholar] [CrossRef]
- Popov, I.; Lewin, G. Methods in Enzymology, 300. In Oxidants and Antioxidants, Part B; Packer, L., Ed.; Academic Press: New York, NY, USA, 1999; p. 437. [Google Scholar]
- Martınez-Tome, M.; Jimenez-Monreal, A.M.; Garcıa-Jimenez, L.; Almela, L.; Garcıa-Diz, L.; Mariscal-Arcas, M.; Murcia, M.A. Assessment of antimicrobial activity of coffee brewed in three different ways from different origins. Eur. Food Res. Technol. 2011, 233, 497–505. [Google Scholar] [CrossRef]
- Dale, A.P.; Woodford, N. Extra-intestinal pathogenic Escherichia coli: Disease, carriage and clones. J. Infect. 2015, 71, 615–626. [Google Scholar] [CrossRef] [PubMed]
- Neculai, A.M.; Sîrbu, R.; Lepădatu, A.C. Study of antimicrobial activity of vegetable alcoholic extracts obtained from Vinca minor L. Eur. J. Med. Nat. Sci. 2020, 4, 66–73. [Google Scholar]
- Abouzeid, S.; Hijazin, T.; Lewerenz, L.; Hansch, R.; Selmar, D. The genuine localization of indole alkaloids in Vinca minor and Catharanthus roseus. Phytochemistry 2019, 168, 110–112. [Google Scholar] [CrossRef]
- Boga, M.; Kolak, U.; Topcu, G.; Bahadori, F.; Kartal, M.; Farnsworth, N.R. Two new indole alkaloids from Vinca herbacea L. Phytochem. Lett. 2011, 4, 399–403. [Google Scholar] [CrossRef]
- Boyadzhiev, L.; Yordanov, B. Pertraction of indole alkaloids from Vinca minor L. Sep. Sci. Technol. 2004, 39, 1321–1329. [Google Scholar] [CrossRef]
- Venkatesham, M.; Ayodhya, D.; Madhusudhan, A.; Veera Babu, N.; Veerabhadram, G.A. Novel green one-step synthesis of silver nanoparticles using chitosan: Catalytic activity and antimicrobial studies. Appl. Nanosci. 2014, 4, 113–119. [Google Scholar] [CrossRef]
- Moldoveanu, D.; Lepădatu, A. Bacteriologie şi Genetică Moleculară; Pegasus Press: Bucureşti, Romania, 2004; pp. 24–35. [Google Scholar]
- Grujić, S.M.; Radojević, I.D.; Vasić, S.M.; Čomić, L.R.; Topuzović, M.D. Antimicrobial activity and some phytochemical analysis of two extracts Vinca minor L. Krag. J. Sci. 2014, 3, 145–154. [Google Scholar] [CrossRef]
- Özçelik, B.; Kartal, M.; Orhan, I. Cytotoxicity, antiviral and antimicrobial activities of alkaloids, flavonoids, and phenolic acids. Pharm. Biol. 2011, 49, 396–402. [Google Scholar] [CrossRef]
- Adamczak, A.; Ożarowski, M.; Karpiński, T.M. Antibacterial Activity of Some Flavonoids and Organic Acids Widely Distributed in Plants. J. Clin. Med. 2020, 9, 109. [Google Scholar] [CrossRef]
- Ganeshpurkar, A.; Saluja, A.K. The pharmacological potential of rutin. Saudi Pharm. J. 2017, 25, 149–164. [Google Scholar] [CrossRef] [PubMed]
- Deepika, M.S.; Thangam, R.; Vijayakumar, T.S.; Sasirekha, R.; Vimala, R.T.V.; Sivasubramanian, S.; Arun, S.; Babu, M.D.; Thirumurugan, R. Antibacterial synergy between rutin and florfenicol enhances therapeutic spectrum against drug resistant Aeromonas hydrophila. Microb. Pathogen. 2019, 135, 103612. [Google Scholar] [CrossRef] [PubMed]
- Popovici, I.; Lupuleasa, D. Tehnologie Farmaceutica, 2nd ed.; Poliron: Iasi, Romania, 2017; Volume 3, p. 580. ISBN 9789734669103. [Google Scholar]
- Tudose, R.Z.; Volintiru, T.; Asandei, N.; Lungu, M.; Merica, E.; Ivan, G. Reologia Compuşilor Macromoleculari. In Introducere În Reologie; Tehnică: Bucureşti, Romania, 1982; Volume 1, pp. 65–70. [Google Scholar]
- Berman, J. Candida albicans. Curr. Biol. 2012, 22, 620–622. [Google Scholar] [CrossRef] [PubMed]
- Ali Khan, B.; Ullah, S.; Khan, M.K.; Alshahrani, S.M.; Braga, V.A. Formulation and evaluation of Ocimum basilicum-based emulgel for wound healing using animal model. Saudi Pharm J. 2020, 28, 1842–1850. [Google Scholar] [CrossRef] [PubMed]
- Basha, B.N.; Prakasam, K.; Goli, D. Formulation and evaluation of Gel containing Fluconazole-Antifungal Agent. Int. J. Drug. Dev. Res. 2011, 3, 119–127. [Google Scholar]
- Burki, I.K.; Khan, M.K.; Khan, B.A.; Uzair, B.; Braga, V.A.; Jamil, Q.A. Formulation development, characterization, and evaluation of a novel dexibuprofen-capsaicin skin emulgel with improved in vivo anti-inflammatory and analgesic effects. AAPS PharmSciTech 2020, 21, 211. [Google Scholar] [CrossRef]
- Artem, V.; Negreanu–Pirjol, T.; Ranca, A.; Ciobanu, C.; Bratu, M.M.; Popoviciu, D.R.; Moldovan, L.; Vasile, M.; Negreanu-Pirjol, B.S. Total phenolic content correlated with antioxidant activity of some grape pomace biomass hydroalcoholic extracts, white and red varieties. Univ. Politeh. Buchar. Sci. Bull. Ser. B-Chem. Mater. Sci. 2021, 83, 61–72. [Google Scholar]
- Stanciu, G.; Lupsor, S.; Tomescu, A.; Sirbu, R. Evaluation of Antioxidant Capacities and Phenols Composition of Wild and Cultivated Berries. Rev. Chim. 2019, 70, 373–377. [Google Scholar] [CrossRef]
- Stanciu, G.; Cristache, N.; Lupsor, S.; Dobrinas, S. Evaluation of antioxidant activity and total phenols content in selected spices. Rev. Chim. 2017, 68, 1429–1434. [Google Scholar] [CrossRef]
- Stanciu, G.; Chirila, E.; Dobrinas, S.; Negreanu-Pirjol, T. Studies regarding the determination of antioxidant properties of new plant extracts for cosmetic purposes. Rev. Chim. 2010, 61, 45. [Google Scholar]
- Bauer, A.W.; Kirby, W.M.; Sherris, J.C.; Turck, M. Antibiotic susceptibility testing by a standardized single disk method. Am. J. Clin. Pathol. 1966, 45, 493–496. [Google Scholar] [CrossRef]
- Humphries, R.; Bobenchik, A.M.; Hindler, J.A.; Schuetz, A.N. Overview of Changes to the Clinical and Laboratory Standards Institute Performance Standards for Antimicrobial Susceptibility Testing, M100, 31st Edition. J. Clin. Microbiol. 2021, 59, e0021321. [Google Scholar] [CrossRef] [PubMed]
- AVMA. Guidelines for the Euthanasia of Animals; American Veterinary Medical Association: Schaumburg, IL, USA, 2013. [Google Scholar]
- OECD. Guidelines for Testing of Chemicals. In Acute Oral Toxicities Up and Down Procedure; OECD: Paris, France, 2001; Volume 425, pp. 1–26. [Google Scholar]
- Mititelu, M.; Licu, M.; Lupu, C.E.; Neacșu, S.M.; Olteanu, G.; Stanciu, G.; Drăgănescu, D.; Oancea, C.-N.; Busnatu, Ș.S.; Hîncu, L.; et al. Characterization of Some Dermato-Cosmetic Preparations with Marine Lipids from Black Sea Wild Stingray. Mar. Drugs 2023, 21, 408. [Google Scholar] [CrossRef] [PubMed]
- Mishra, P.; Singh, U.; Pandey, C.M.; Mishra, P.; Pandey, G. Application of student’s t-test, analysis of variance, and covariance. Ann. Card. Anaesth. 2019, 22, 407–411. [Google Scholar] [CrossRef]
- Leahu, A.; Lupu, E.C. Statistical simulation and prediction in software reliability. Analele Univ. Ovidius Constanţa Ser. Mat. 2008, 16, 81–90. [Google Scholar]
- Mititelu, M.; Stanciu, G.; Drăgănescu, D.; Ioniță, A.C.; Neacșu, S.M.; Dinu, M.; Stefanvan Staden, R.-I.; Moroșan, E. Mussel Shells, a Valuable Calcium Resource for the Pharmaceutical Industry. Mar. Drugs 2022, 20, 25. [Google Scholar] [CrossRef]

| Characteristic | P1 | P2 | P3 | P4 | P5 | P6 |
|---|---|---|---|---|---|---|
| Initial macroscopic characteristics | Homogeneous product; greenish color; specific smell | Homogeneous product; creamy white color; specific smell | Homogeneous product; creamy white color; specific smell | Homogeneous product; white color; specific smell | Homogeneous product; greenish color; specific smell | Homogeneous product; creamy white color; specific smell |
| Macroscopic characteristics after 30 days | In the initial form | In the initial form | In the initial form | In the initial form | In the initial form | In the initial form |
| Initial pH | 5.8 | 6.7 | 5.8 | 6.7 | 6.2 | 6.2 |
| pH after 30 days | 5.5 | 6.5 | 5.6 | 6.6 | 5.8 | 5.9 |
| Initial thermal stability | Stable, homogeneous product | Stable, homogeneous product | Stable, homogeneous product | Stable, homogeneous product | Stable, homogeneous product | Stable, homogeneous product |
| Thermal stability after 30 days | Stable, homogeneous product | Stable, homogeneous product | Stable, homogeneous product | Stable, homogeneous product | Stable, homogeneous product | Stable, homogeneous product |
| Characteristic | P7 | P8 | P9 | P10 | P11 | P12 |
|---|---|---|---|---|---|---|
| Initial macroscopic characteristics | Homogeneous product; greenish color; specific smell | Homogeneous product; greenish color; specific smell | Homogeneous product; green color; specific smell | Homogeneous product; greenish color; specific smell | Homogeneous product; green color; specific smell | Homogeneous product; greenish color; specific smell |
| Macroscopic characteristics after 30 days | In the initial form | In the initial form | In the initial form | In the initial form | In the initial form | In the initial form |
| Initial pH | 5.8 | 6.7 | 6.1 | 5.4 | 6.4 | 6.7 |
| pH after 30 days | 5.6 | 6.4 | 5.8 | 5.2 | 6.1 | 6.5 |
| Initial thermal stability | Stable, homogeneous product | Stable, homogeneous product | Stable, homogeneous product | Stable, homogeneous product | Stable, homogeneous product | Stable, homogeneous product |
| Thermal stability after 30 days | Stable, homogeneous product | Stable, homogeneous product | Stable, homogeneous product | Stable, homogeneous product | Stable, homogeneous product | Stable, homogeneous product |
| Sample | Shear Spead D (s−1) the Interval | Viscosity ƞ (cP) the Interval | Shear Stress τ (mPa) the Interval |
|---|---|---|---|
| P1 | 1.7–68 | 1493–17,541 | 28,090–102,400 |
| P2 | 2.04–68 | 2150–25,640 | 51,102–146,200 |
| P3 | 1.02–17 | 30,800–105,100 | 107,202–351,900 |
| P4 | 2.04–68 | 2200–33,198 | 66,500–150,280 |
| P5 | 3.4–68 | 609–45,212 | 41,400–153,720 |
| P6 | 3.4–68 | 1300–12,100 | 1,690,000–146,410,000 |
| P7 | 1.7–68 | 1430–47,950 | 67,666.8–175,100 |
| P8 | 4.08–20.04 | 12,800–35,200 | 141,168–271,150 |
| P9 | 1.02–68 | 4498–72,000 | 72,420–306,000 |
| P10 | 2.04–34 | 8400–102,900 | 193,016–399,600 |
| P11 | 2.04–68 | 4600–56,450 | 105,056–458,800 |
| P12 | 3.4–68 | 4600–43,335 | 141,576–312,800 |
| Biocomposites/Rheological Model | K Consistency Coefficient | n Flow Coefficient | R Correlation Coefficient Ostwald de Waele |
|---|---|---|---|
| P1 | 10.406 | 0.3454 | 0.9988 |
| P2 | 10.564 | 0.292 | 0.9953 |
| P3 | 11.344 | 0.7066 | 0.9979 |
| P4 | 10.941 | 0.2345 | 0.9993 |
| P5 | 12.388 | 0.5687 | 0.9992 |
| P6 | 20.787 | 0.5027 | 0.9962 |
| P7 | 11.282 | 0.1800 | 0.9962 |
| P8 | 10.647 | 0.374 | 0.9992 |
| P9 | 11.5312 | 0.24483 | 0.9970 |
| P10 | 11.83 | 0.4038 | 0.9972 |
| P11 | 11.540 | 0.294 | 0.9976 |
| P12 | 11.9 | 0.1841 | 0.9976 |
| No | Sample/Dilution/Working Volume | Free Radicals Max. Inhibition | Total Antioxidant Capacity (nM TE/μL) | TEAC Quantity Means (mg TE/100 g Sample) |
|---|---|---|---|---|
| 1 | P3/stock sol./5 μL; | 0.945 | −3.304 | - |
| 2 | P3/dil. with ethanol 1:100/5 μL; | 0.443 | 1.959 | 9804.795 |
| 3 | P4/stock sol./5 μL; | 0.189 | 0.388 | 19.419 |
| 4 | P9/stock sol./5 μL; | 0.894 | −3.819 | - |
| 5 | P9/dil. with ethanol 1:100/5 μL; | 0.275 | 0.692 | 3463.46 |
| 6 | P10/stock sol./5 μL; | 0.228 | 0.512 | 25.625 |
| Components | P1 1 | P2 1 | P3 1 | P4 1 | P5 1 | P6 1 |
|---|---|---|---|---|---|---|
| Distilled water | 10.3% | 20.5% | 26.5% | 21.2% | 26.8% | 27.1% |
| Hydroalcoholic macerate 40% | - | - | - | - | 25% | 21.3% |
| Hydroalcoholic macerate 70% | - | - | 24.8% | 24.8% | - | - |
| Hydroalcoholic macerate 96% | 16.2% | 16% | - | - | - | - |
| Citric acid | 2.6% | - | - | - | - | - |
| Hyaluronic acid | 1% | - | - | - | - | - |
| Lanolin | 62.1% | 36% | 37% | 37% | 37.5% | 27.1% |
| Ag sulfadiazine | 2.6% | 5.1% | 5.3% | 5.3% | - | 6.8% |
| Cetyl alcohol | 2.6% | 3% | 3.7% | 3.7% | 10.7% | 4.1% |
| Vaseline | - | 10.3% | - | - | - | - |
| Shea butter | - | 5.1% | - | - | - | - |
| Vitamin E | - | 1% | - | - | - | - |
| Vegetable collagen | 2.6% | - | - | - | - | - |
| Collagen from Nisetru fish | - | - | - | - | - | 6.8% |
| Stearic acid | - | - | 2.7% | 2.7% | - | - |
| Zinc oxide | - | 3% | - | 5.3% | - | 6.8% |
| Components | P7 1 | P8 1 | P9 1 | P10 1 | P11 1 | P12 1 |
|---|---|---|---|---|---|---|
| Distilled water | 18.7% | 20% | 26.5% | 21.2% | 27.6% | 26.8% |
| Hydroalcoholic macerate 40% | - | - | - | - | 17.3% | 21% |
| Hydroalcoholic macerate 70% | - | - | 24.8% | 24.8% | - | - |
| Hydroalcoholic macerate 96% | 14.8% | 15.6% | - | - | - | - |
| Citric acid | 2.3% | - | - | - | - | - |
| Hyaluronic acid | 1% | - | - | - | - | 1.3% |
| Lanolin | 56% | 35% | 37% | 37% | 44.1% | 26.8% |
| Ag sulfadiazine | 2.7% | 5% | 5.3% | 5.3% | - | 6.7% |
| Cetyl alcohol | 2.3% | 3.4% | 3.7% | 3.7% | 11% | 4% |
| Vaseline | - | 10% | - | - | - | - |
| Shea butter | - | 5% | - | - | - | - |
| Vitamin E | - | 1% | - | - | - | - |
| Vegetable collagen | 2.2% | - | - | - | - | - |
| Collagen from Nisetru fish | - | - | - | - | - | 6.7% |
| Stearic acid | - | - | 2.7% | 2.7% | - | - |
| Zinc oxide | - | 5% | - | 5.3% | - | 6.7% |
| Reagents Kit | R1 (μL) | R2 (μL) | R3 (μL) | R4 (μL) | Sample (μL) |
|---|---|---|---|---|---|
| Blank | 2300 µL | 200 µL | 25 µL | 0 µL | 0 µL |
| Calibration curve | 2300 µL | 200 µL | 25 µL | 5 µL | 0 µL |
| Measurement Sample | 2300 µL | 200 µL | 25 µL | 0 µL | 5 µL |
Disclaimer/Publisher’s Note: The statements, opinions and data contained in all publications are solely those of the individual author(s) and contributor(s) and not of MDPI and/or the editor(s). MDPI and/or the editor(s) disclaim responsibility for any injury to people or property resulting from any ideas, methods, instructions or products referred to in the content. |
© 2023 by the authors. Licensee MDPI, Basel, Switzerland. This article is an open access article distributed under the terms and conditions of the Creative Commons Attribution (CC BY) license (https://creativecommons.org/licenses/by/4.0/).
Share and Cite
Neculai, A.-M.; Stanciu, G.; Lepădatu, A.C.; Cima, L.-M.; Mititelu, M.; Neacșu, S.M. Development of New Dermato-Cosmetic Therapeutic Formulas with Extracts of Vinca minor L. Plants from the Dobrogea Region. Int. J. Mol. Sci. 2023, 24, 16234. https://doi.org/10.3390/ijms242216234
Neculai A-M, Stanciu G, Lepădatu AC, Cima L-M, Mititelu M, Neacșu SM. Development of New Dermato-Cosmetic Therapeutic Formulas with Extracts of Vinca minor L. Plants from the Dobrogea Region. International Journal of Molecular Sciences. 2023; 24(22):16234. https://doi.org/10.3390/ijms242216234
Chicago/Turabian StyleNeculai, Ana-Maria, Gabriela Stanciu, Anca Cristina Lepădatu, Luiza-Madălina Cima, Magdalena Mititelu, and Sorinel Marius Neacșu. 2023. "Development of New Dermato-Cosmetic Therapeutic Formulas with Extracts of Vinca minor L. Plants from the Dobrogea Region" International Journal of Molecular Sciences 24, no. 22: 16234. https://doi.org/10.3390/ijms242216234
APA StyleNeculai, A.-M., Stanciu, G., Lepădatu, A. C., Cima, L.-M., Mititelu, M., & Neacșu, S. M. (2023). Development of New Dermato-Cosmetic Therapeutic Formulas with Extracts of Vinca minor L. Plants from the Dobrogea Region. International Journal of Molecular Sciences, 24(22), 16234. https://doi.org/10.3390/ijms242216234

